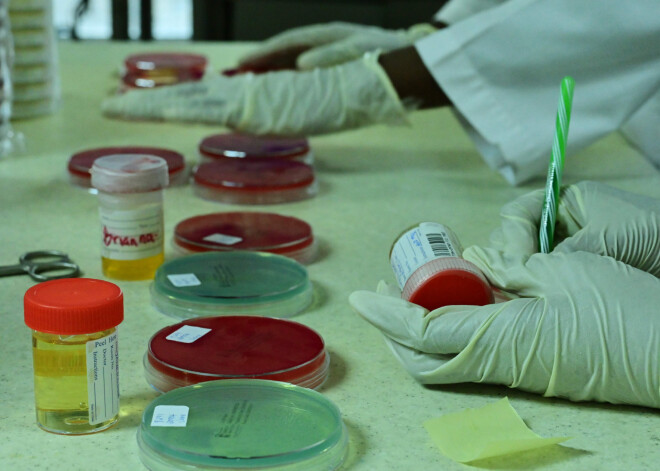

Citi sporta veidi
2019. gada 1. oktobrī, 08:33
Latvijā oficiāli stājas spēkā starptautiskās prasības antidopinga jomā
Ar šodienu Latvijā oficiāli stājas spēkā starptautiskās prasības antidopinga jomā, liecina Nacionālie antidopinga noteikumi.
Nacionālajos antidopinga noteikumos turpmāk būs noteikti antidopinga noteikumu pārkāpumi, reglamentēta to pierādīšanas kārtība un termiņi, rezultātu anulēšana un sankcijas, kā arī noteikta kārtība un termiņi, kādos sportists var iesniegt pieteikumu Terapeitiskās lietošanas izņēmumu komisijai.
Vienlaikus noteikumi nosaka kārtību un termiņus, kādos Latvijas Antidopinga birojs vēršas Disciplinārajā antidopinga komisijā, kā arī kārtību un termiņus, kādos Disciplinārā antidopinga komisija izskata iespējamos antidopinga noteikumu pārkāpumus un pieņem par tiem lēmumus.
Tāpat noteikumi nosaka kārtību, kādā iesniedz un izskata pārsūdzības par antidopinga jomā iesaistīto institūciju pieņemtajiem lēmumiem.